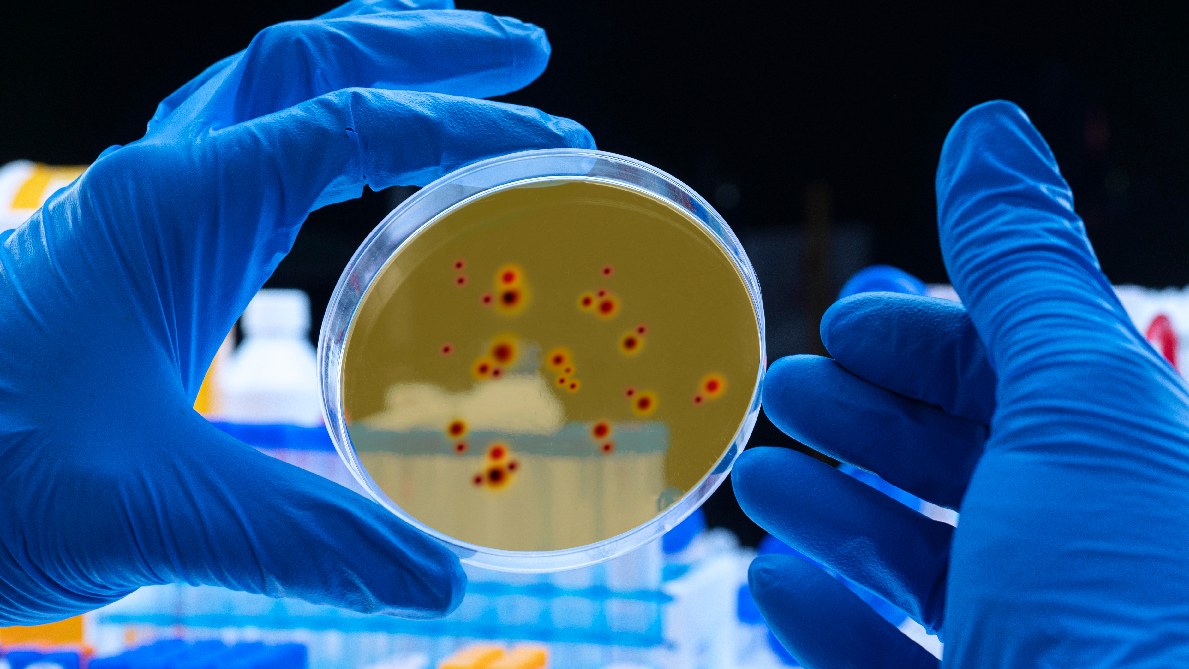

Buscar

yext
digicomphoto Propietario verificado
Calle Girasol, 47 23620, MengíbarÚltima actualización: 10/2/25, 3:16 AM
Imágenes

Preguntas frecuentes
Que dias esta digicomphoto abierto?
Abierto los Lunes, Martes, Miércoles, Jueves, Viernes, Sábado, Domingo.
¡Atención dueños!
Registra tu comercio ahora e incrementa tu alcance global con iGlobal.
Copiado al portapapeles!